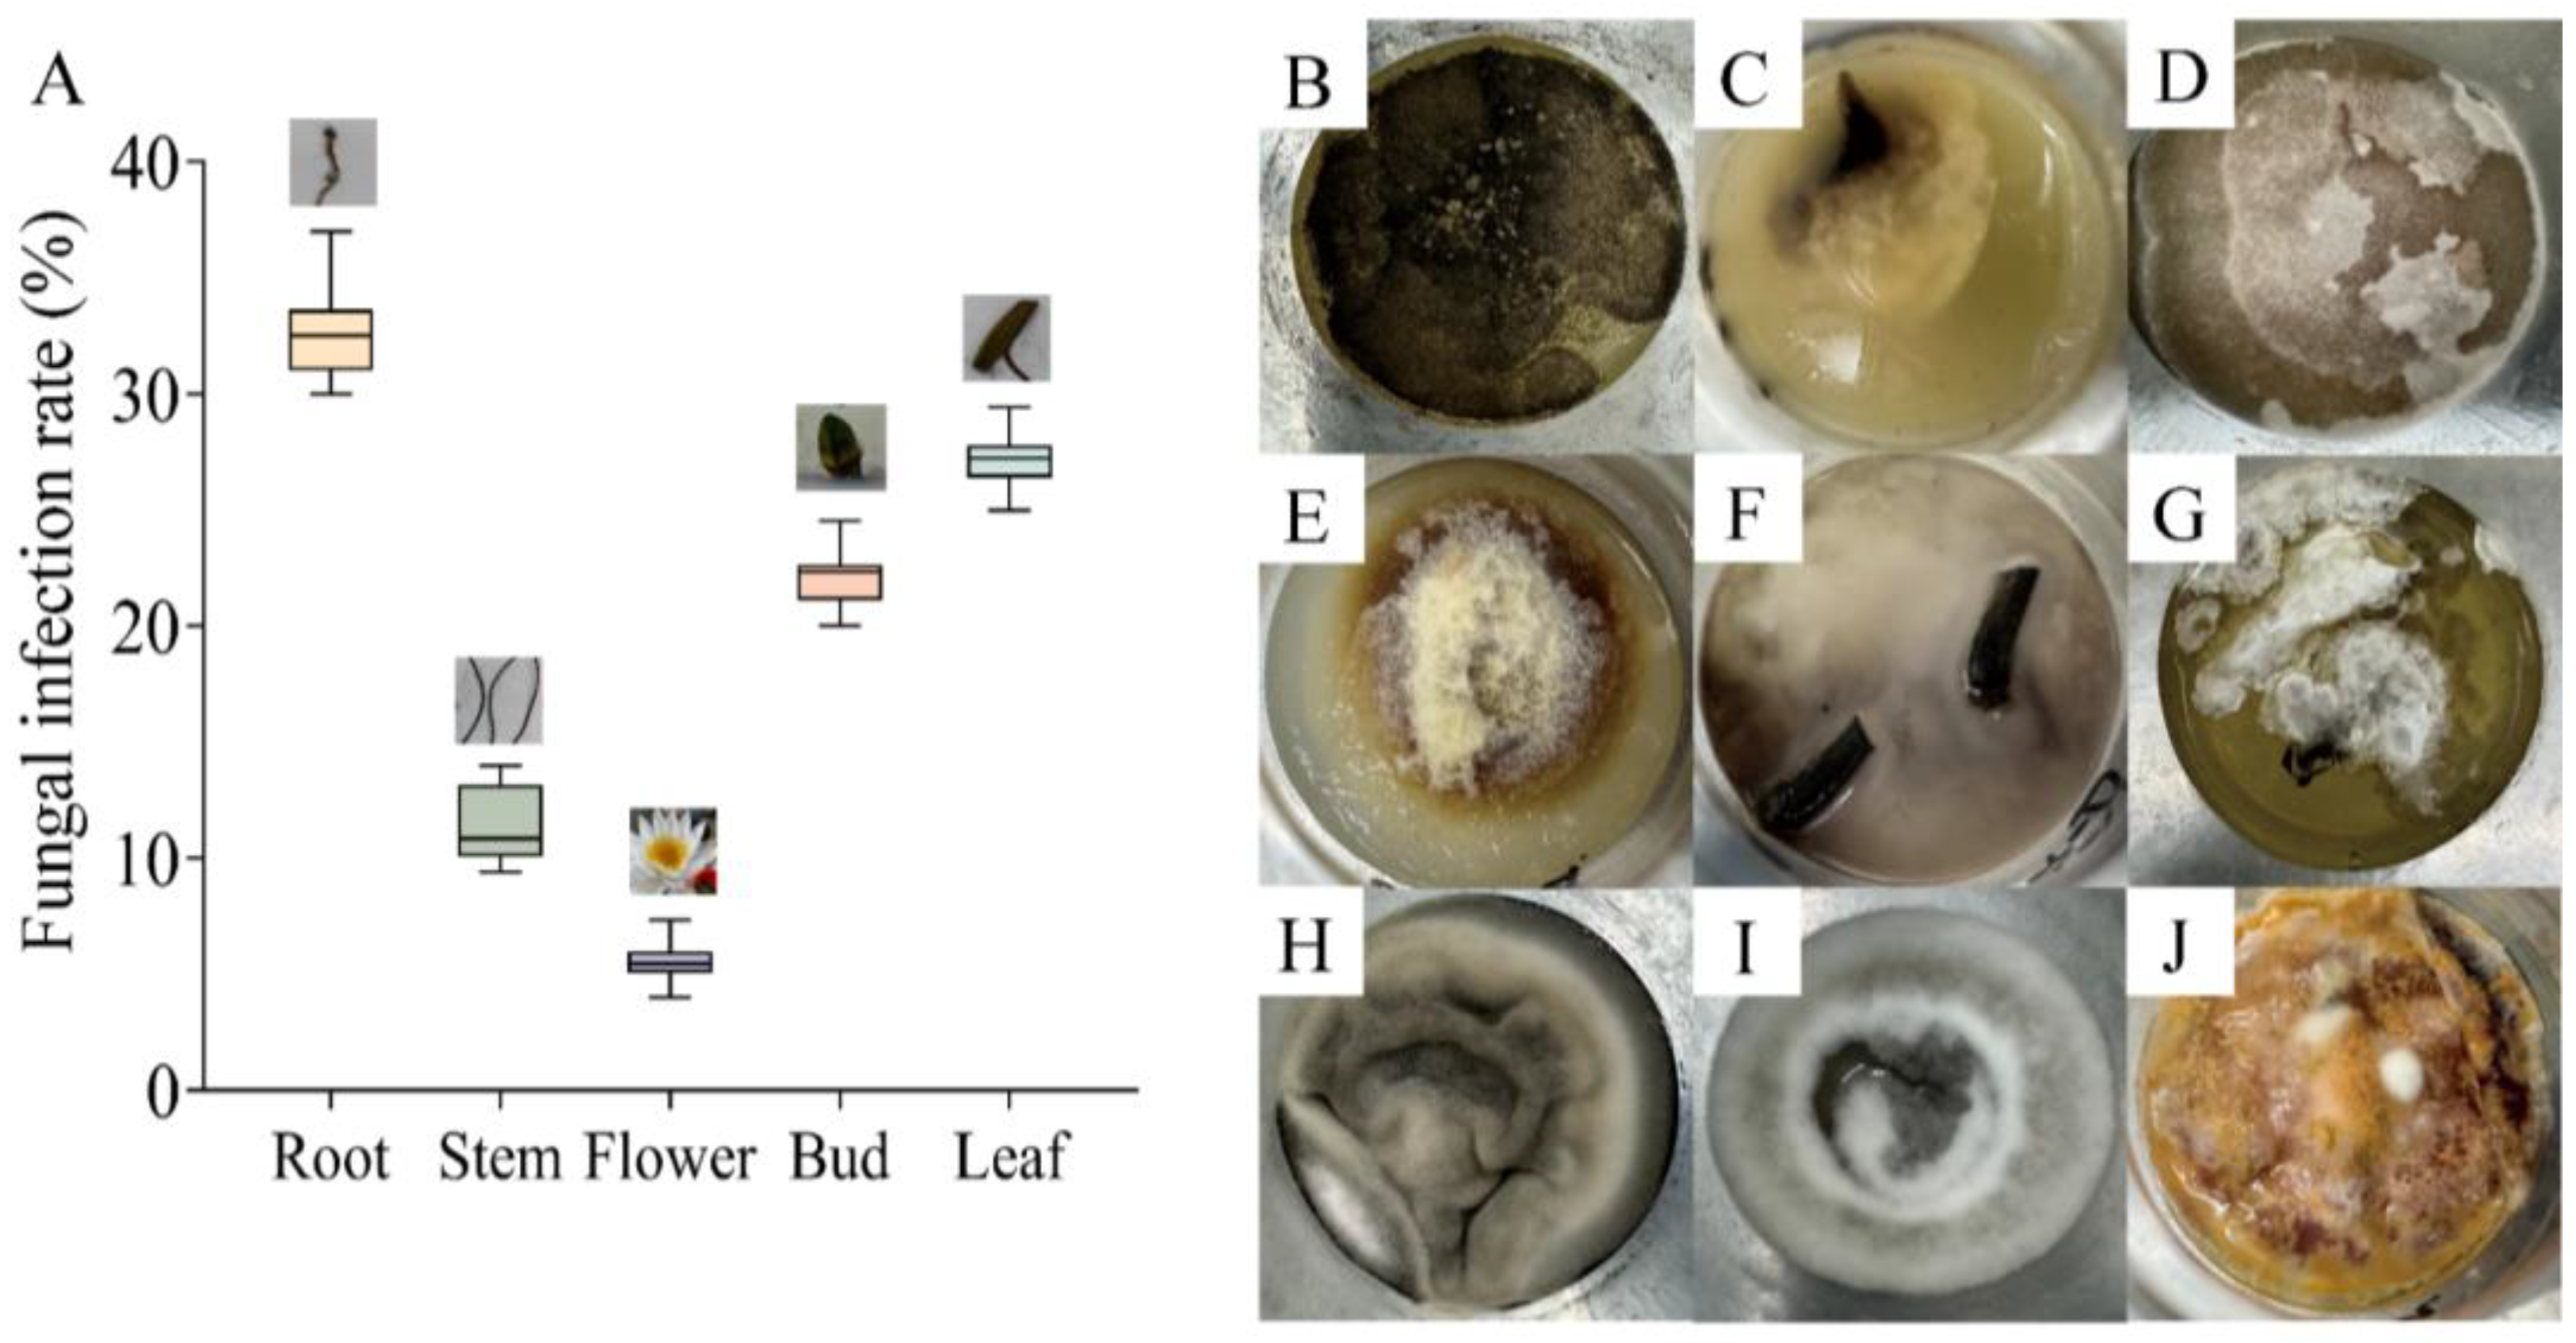
Microorganisms 13 01103 g001

Isolation, Identification, and Control of Pathogenic Endophytic Fungi in Nymphaea candida Presl Tissue Culture
Abstract
1. Introduction
2. Materials and Methods
2.1. Biomaterials and Reagents
2.2. Tissue Culture of N. candida and Fungal Contamination
2.3. DNA Extraction and Amplicon Determination of Endophytic Fungi in Roots, Stems, and Leaves of N. candida
2.4. Isolation and Purification of Endophytic Fungi
2.5. Identification of Endophytic Fungi and Construction of a Phylogenetic Tree
2.6. Inhibitory Effect of Different Drugs on Pathogenic Endophytic Fungi
2.7. Application of Antifungal Drugs in Tissue Culture
2.8. Statistical Analysis of the Data
3. Results
3.1. Fungal Contamination in Tissue Culture of N. candida
3.2. Biodiversity and Community Composition of Endophytic Fungi in the Tissues of N. candida
3.3. Identification of Endophytic Fungi in N. candida
3.4. The Inhibition Effects of Five Drugs on Pathogenic Endophytic Fungi
3.5. Application of Fungicide Combination in Tissue Culture
4. Discussion
4.1. Pathogenic Endophytic Fungi in N. candida Tissues
4.2. Development and Validation of an Antifungal Formulation for Tissue Culture of N. candida
5. Conclusions
Supplementary Materials
Author Contributions
Funding
Institutional Review Board Statement
Informed Consent Statement
Data Availability Statement
Acknowledgments
Conflicts of Interest
References
- Li, S.J.; Wei, Q.; Chen, C.; Zhang, Y.; Wu, Y.K.; Chen, G. Breeding progress of water lilies in China. J. Plant Genet. Res. 2019, 20, 829–835. [Google Scholar] [CrossRef]
- Yin, D.D.; Yuan, R.Y.; Wu, Q.; Li, S.S.; Shao, S.; Xu, Y.J.; Hao, X.H.; Wang, L.S. Assessment of flavonoids and volatile compounds in tea infusions of water lily flowers and their antioxidant activities. Food Chem. 2015, 187, 20–28. [Google Scholar] [CrossRef]
- Baasanmunkh, S.; Oyuntsetseg, B.; Urgamal, M.; Norris, J.; Shiga, T.; Choi, H.J. Notes on the taxonomy of Nymphaeaceae and Menyanthaceae in Mongolia. J. Asia-Pac. Biodivers. 2022, 15, 129–137. [Google Scholar] [CrossRef]
- Taoerdahong, H.; Kadeer, G.; Chang, J.; Kang, J.; Ma, X.L.; Yang, F. A review concerning the polysaccharides found in edible and medicinal plants in Xinjiang. Molecules 2023, 28, 2054. [Google Scholar] [CrossRef]
- Monder, M.J.; Pacholczak, A.; Zajączkowska, M. Directions in Ornamental Herbaceous Plant Selection in the Central European Temperate Zone in the Time of Climate Change: Benefits and Threats. Agriculture 2024, 14, 2328. [Google Scholar] [CrossRef]
- Ma, X.Q.; Wang, Y.; Wang, X.; Yang, M.H.; Ye, C.X.; Yang, Z.J.; Xu, Y.C. Comparative transcriptome analysis reveals the regulatory mechanisms of two tropical water lilies in response to cold stress. Biomed. Cent. Genom. 2023, 24, 82. [Google Scholar] [CrossRef]
- Arefin, M.A.; Rashid, F.; Islam, A. A review of biofuel production from floating aquatic plants: An emerging source of bio-renewable energy. Biofuels Bioprod. Biorefining 2021, 15, 574–591. [Google Scholar] [CrossRef]
- Ikeuchi, M.; Ogawa, Y.; Sugimoto, K.; Ikeuchi, M.; Ogawa, Y.; Iwase, A.; Sugimoto, K. Plant regeneration: Cellular origins and molecular mechanisms. Development 2016, 143, 1442–1451. [Google Scholar] [CrossRef]
- Rahman, N.; Dhadi, S.R.; Deshpande, A.; Ramakrishna, W. Rice callus suspension culture inhibits growth of cell lines of multiple cancer types and induces apoptosis in lung cancer cell line. BMC Complement. Altern. Med. 2016, 16, 427. [Google Scholar] [CrossRef]
- Sacu, M.; Aktas, L.Y.; Bayraktar, M.; Gurel, A. Growth and antioxidant defence in hypocotyl-derived calli of two cotton cultivars with contrasting salt tolerance. Plant Cell Tissue Organ Cult. 2023, 154, 297–309. [Google Scholar] [CrossRef]
- Chandimali, N.; Park, E.H.; Bak, S.J.; Lim, H.J.; Won, Y.S.; Lee, S.J. Seaweed callus culture: A comprehensive review of current circumstances and future perspectives. Algal Res. 2023, 77, 103376. [Google Scholar] [CrossRef]
- Verma, R.; Yadav, A.; Sanyal, I.; Gupta, R.K. Development of a high-frequency in vitro regeneration system in Indian lotus (Nelumbo nucifera Gaertn.). Vitr. Cell. Dev. Biol.-Plant 2024, 60, 763–764. [Google Scholar] [CrossRef]
- Dogan, M. The effectiveness of light emitting diodes on shoot regeneration in vitro from shoot tip tissues of Limnophila aromatica (Lamk.) Merr. and Rotala rotundifolia (Buch-Ham. ex Roxb) Koehne. Biotech. Histochem. 2020, 95, 225–232. [Google Scholar] [CrossRef]
- Sherif, N.A.; Kumar, T.S.; Rao, M.V. In vitro regeneration by callus culture of Anoectochilus elatus Lindley, an endangered terrestrial jewel orchid. Vitr. Cell. Dev. Biol.-Plant 2016, 52, 72–80. [Google Scholar] [CrossRef]
- Sheikholeslami, B.; Shukla, M.; Turi, C.; Harpur, C.; Saxena, P.K. Saving threatened plant species: Reintroduction of Hill’s thistle (Cirsium hillii. (Canby) Fernald) to its natural habitat. PLoS ONE 2020, 15, e0231741. [Google Scholar] [CrossRef] [PubMed]
- Edesi, J.; Tolonen, J.; Aspi, J.; Häggman, H. Cryopreservation enables long-term conservation of critically endangered species Rubus humulifolius. Biodivers. Conserv. 2020, 29, 303–314. [Google Scholar] [CrossRef]
- Kim, D.H.; Gopal, J.; Sivanesan, I. Nanomaterials in plant tissue culture: The disclosed and undisclosed. RSC Adv. 2017, 7, 36492–36505. [Google Scholar] [CrossRef]
- Nazir, K.; Hassan, S.W.; Khan, M.I.; Elamin, K.M.A.; Niyazi, H.A. The use of ZnO NPs and Ag NPs along with sterilizing agents for managing contamination in banana tissue culture. Biomass Convers. Biorefinery 2023, 14, 30297–30304. [Google Scholar] [CrossRef]
- Li, W.; Zhu, M.Q.; Zhang, Y.L.; Zhou, R.; Zhao, Z.Y.; Guo, Y.N.; Sun, Y. Isolation, identification and pollution prevention of bacteria and fungi during the tissue culture of Dwarf Hygro (Hygrophila polysperma) explants. Microorganisms 2022, 10, 2476. [Google Scholar] [CrossRef]
- Zhou, X.; Wang, J.; Cai, L. Cross-kingdom synthetic microbiota supports tomato suppression of Fusarium wilt disease. Nat. Commun. 2022, 13, 7890. [Google Scholar] [CrossRef]
- Ahmad, R.Z.; Husni, A.; Bakrie, B. Effects of Essential Oil Made of Orange Peels on Fungal Contamination of Elephant Grass, Cassava Plant and Corn Kernel Explants on Tissue Culture Medium. In IOP Conference Series: Earth and Environmental Science, Proceedings of the 4th Animal Production International Seminar, Malang, Indonesia, 24–27 October 2019; IOP Publishing Ltd.: Bristol, UK, 2020; pp. 1–8. [Google Scholar] [CrossRef]
- Khan, T.; Abbasi, B.H.; Khan, M.A.; Shinwari, Z.K. Molecular identification and control of endophytic contamination during in vitro plantlet development of Fagonia indica. Acta Physiol. Plant. 2018, 40, 1–9. [Google Scholar] [CrossRef]
- Kumar, S.; Yadav, A.K.; Prabha, C. Microbial contamination in tissue culture of Chlorophytum borivilianum, a rare medicinal herb: Identification and prevention. J. Plant Pathol. 2019, 101, 991–995. [Google Scholar] [CrossRef]
- Abass, M.H. Molecular identification of fungal contamination in date palm tissue cultures. In Date Palm Biotechnology Protocols Volume II: Germplasm Conservation and Molecular Breeding; Humana: New York, NY, USA, 2017; pp. 91–101. [Google Scholar] [CrossRef]
- Li, X.; Li, Y.; Wang, Y.; Liu, Y.Y.; Riaz, L.Q.; Wang, Q.Q.; Zeng, X.P.; Qin, Z.; Irfan, M.; Wang, Y. Methodology comparison of environmental sediment fungal community analysis. Environ. Res. 2024, 263, 120260. [Google Scholar] [CrossRef]
- Savi, D.C.; Shaaban, K.A.; Mitra, P.; Ponomareva, L.V.; Thorson, J.S.; Glienke, C.; Rohr, J. Secondary metabolites produced by the citrus phytopathogen Phyllosticta citricarpa. J. Antibiot. 2019, 72, 306–310. [Google Scholar] [CrossRef] [PubMed]
- Wang, M.; Xu, Z.; Huang, Y.; Dong, B. Investigation of Cd (II) removal mechanism during biogenic Mn (II) oxidation by Cladosporium sp. XM01. Chem. Eng. J. 2024, 496, 153801. [Google Scholar] [CrossRef]
- Dai, Y.; Wang, Z.; Leng, J.; Sui, Y.; Jiang, M.; Wisniewski, M.; Liu, J.; Wang, Q. Eco-friendly management of postharvest fungal decays in kiwifruit. Crit. Rev. Food Sci. Nutr. 2022, 62, 8307–8318. [Google Scholar] [CrossRef] [PubMed]
- De Cock, A.W.; Lodhi, A.M.; Rintoul, T.L.; Bala, K.; Robideau, G.P.; Abad, Z.G.; Coffey, M.D.; Shahzad, S.; Lévesque, C.A. Phytopythium: Molecular phylogeny and systematics. Persoonia-Mol. Phylogeny Evol. Fungi 2015, 34, 25–39. [Google Scholar] [CrossRef]
- Yasemin, S.; Beruto, M. A Review on Flower Bulb Micropropagation: Challenges and Opportunities. Horticulturae 2024, 10, 284. [Google Scholar] [CrossRef]
- Murthy, H.N.; Joseph, K.S.; Park, S.Y.; Park, S.Y. Bioreactor systems for micropropagation of plants: Present scenario and future prospects. Front. Plant Sci. 2023, 14, 1159588. [Google Scholar] [CrossRef]
- Gai, Y.; Ma, H.; Li, H. Chromosome-scale genome sequence of Alternaria alternata causing Alternaria brown spot of citrus. Mol. Plant-Microbe Interact. 2021, 34, 726–732. [Google Scholar] [CrossRef]
- Nuñez-García, P.R.; Vieira, W.A.; Cruz-Lachica, I.; García-Estrada, R.S.; Marquez-Zequera, I.; Márquez-Licona, G.; Tovar-Pedraza, J.M. Occurrence of Phytopythium helicoides Causing Root and Crown Rot of Blueberry in Mexico. J. Phytopathol. 2024, 172, e13403. [Google Scholar] [CrossRef]
- Hao, Y.; Rasheed, A.; Zhu, Z.; Nuñez-García, P.R.; Vieira, W.A.; Cruz-Lachica, I.; García-Estrada, R.S.; Marquez-Zequera, I.; Márquez-Licona, G.; Tovar-Pedraza, J.M. Harnessing wheat Fhb1 for Fusarium resistance. Trends Plant Sci. 2020, 25, 1–3. [Google Scholar] [CrossRef] [PubMed]
- Zhao, X.; Song, L.; Jiang, L.; Zhu, Y.; Gao, Q.; Wang, D.; Li, M. The integration of transcriptomic and transgenic analyses reveals the involvement of the SA response pathway in the defense of chrysanthemum against the necrotrophic fungus Alternaria sp. Hortic. Res. 2020, 7, 80. [Google Scholar] [CrossRef] [PubMed]
- El-Banna, A.N.; El-Mahrouk, M.E.; Dewir, Y.H.; Farid, M.A.; Abou Elyazid, D.M.; Schumacher, H.M. Endophytic bacteria in banana in vitro cultures: Molecular identification, antibiotic susceptibility, and plant survival. Horticulturae 2021, 7, 526. [Google Scholar] [CrossRef]
- Dwivedi, S.K.; Prasad, G. Integrated management of Sclerotium rolfsii: An overview. Eur. J. Biomed. Pharm. Sci. 2016, 3, 137–146. [Google Scholar]
- Singh, S.; Singh, N.; Kumar, V.; Datta, S.; Wani, A.B.; Singh, D.; Singh, J. Toxicity, monitoring and biodegradation of the fungicide carbendazim. Environ. Chem. Lett. 2016, 14, 317–329. [Google Scholar] [CrossRef]
- Proto, A.; Zarrella, I.; Cucciniello, R.; Pironti, C.; De Caro, F.; Motta, O. Bactericidal and fungicidal activity in the gas phase of sodium dichloroisocyanurate (NaDCC). Curr. Microbiol. 2016, 73, 287–291. [Google Scholar] [CrossRef]
- Adhikary, N.K.; Roy, K. Integrated management of foliar diseases of sesame (Sesamum indicum L.) in coastal Bengal. Int. J. Chem. Stud. 2019, 7, 417–419. [Google Scholar]
- Huang, Q.; Lu, Q.; Fu, J.; Huang, Q.; Lu, Q.; Cao, F.; Li, X.; Wu, X.; Sun, H.; Zhang, J.; et al. Study on the use of Imazalil to continuous crop obstacle of Ganoderma lucidum caused by Xylogone ganodermophthora. Chem. Biol. Technol. Agric. 2024, 11, 57. [Google Scholar] [CrossRef]
- Ren, X.X.; Chen, L.; Su, X.Y.; Ye, Z.H. Development and application of a novel suspension concentrate for seed coating of rice for controlling bakanae disease and seedling rot disease. Front. Bioeng. Biotechnol. 2024, 12, 1418313. [Google Scholar] [CrossRef]
- Liu, S.; Fu, L.; Wang, S.; Chen, J.; Jiang, J.; Che, Z.; Chen, G. Carbendazim resistance of Fusarium graminearum from Henan wheat. Plant Dis. 2019, 103, 2536–2540. [Google Scholar] [CrossRef]
- Lu, J.J.; Ali, A.; He, E.Q.; Yan, G.Q.; Arak, T.U.; Gao, S.J. Establishment of an open, sugar-free tissue culture system for sugarcane micropropagation. Sugar Tech 2020, 22, 8–14. [Google Scholar] [CrossRef]
- Mahanta, M.; Gantait, S. Trends in plant tissue culture and genetic improvement of gerbera. Hortic. Plant J. 2024, 11, 974–988. [Google Scholar] [CrossRef]

Disclaimer/Publisher’s Note: The statements, opinions and data contained in all publications are solely those of the individual author(s) and contributor(s) and not of MDPI and/or the editor(s). MDPI and/or the editor(s) disclaim responsibility for any injury to people or property resulting from any ideas, methods, instructions or products referred to in the content. |
© 2025 by the authors. Licensee MDPI, Basel, Switzerland. This article is an open access article distributed under the terms and conditions of the Creative Commons Attribution (CC BY) license (https://creativecommons.org/licenses/by/4.0/).
Share and Cite
Xing, Y.; Liu, C.; Cui, X.; Lv, H.; Wang, J. Isolation, Identification, and Control of Pathogenic Endophytic Fungi in Nymphaea candida Presl Tissue Culture. Microorganisms 2025, 13, 1103. https://doi.org/10.3390/microorganisms13051103
Xing Y, Liu C, Cui X, Lv H, Wang J. Isolation, Identification, and Control of Pathogenic Endophytic Fungi in Nymphaea candida Presl Tissue Culture. Microorganisms. 2025; 13(5):1103. https://doi.org/10.3390/microorganisms13051103
Chicago/Turabian StyleXing, Yuwei, Cong Liu, Xumeng Cui, Haonan Lv, and Jun Wang. 2025. "Isolation, Identification, and Control of Pathogenic Endophytic Fungi in Nymphaea candida Presl Tissue Culture" Microorganisms 13, no. 5: 1103. https://doi.org/10.3390/microorganisms13051103
APA StyleXing, Y., Liu, C., Cui, X., Lv, H., & Wang, J. (2025). Isolation, Identification, and Control of Pathogenic Endophytic Fungi in Nymphaea candida Presl Tissue Culture. Microorganisms, 13(5), 1103. https://doi.org/10.3390/microorganisms13051103
